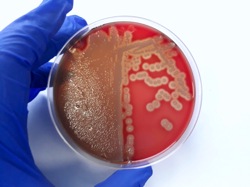
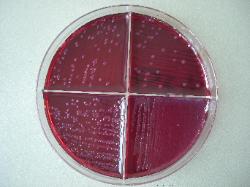

| F4 (K88) - positive E. coli by slide agglutination test |
| Escherichia coli beta-haemolytic colonies on Sheep Blood Agar |
| Escherichia coli |
| Escherichia coli, Gram-negative rods |
| E. coli lactose-positive colonies on Mac Conkey agar |
Taxonomy
Morphology
Cultural characteristics
Biochemical characters
Ecology
Pathogenicity
References
Phylum Pseudomonadota (Proteobacteria), Class Gammaproteobacteria, Order Enterobacterales, Family Enterobacteriaceae,
Genus Escherichia, Escherichia coli (Migula 1895) Castellani and Chalmers 1919, type species of the genus.
Old synonyms: "Bacterium coli commune" Escherich 1885, "Bacillus coli" Migula 1895.
Genus Escherichia, Escherichia coli (Migula 1895) Castellani and Chalmers 1919, type species of the genus.
Old synonyms: "Bacterium coli commune" Escherich 1885, "Bacillus coli" Migula 1895.
Gram-negative, 0.5-1.5 x 2.0-6.0 μm, straight, bacilli or coccobacilli. Non-spore-
forming. Motile by peritrichous flagella or non-motile.
forming. Motile by peritrichous flagella or non-motile.
Colonies on Nutrient agar may be smooth (S type), low convex, shiny surface, entire
edge, gray. R type or mucoid forms may occur. Haemolysis is variable among E. coli
strains. Non-pigmented. Aerobic, facultatively anaerobic. Optimum growth
temperature 37 ºC. Grow readily on simple nutrient media like Nutrient agar or
nutrient broth. No growth on KCN medium.
edge, gray. R type or mucoid forms may occur. Haemolysis is variable among E. coli
strains. Non-pigmented. Aerobic, facultatively anaerobic. Optimum growth
temperature 37 ºC. Grow readily on simple nutrient media like Nutrient agar or
nutrient broth. No growth on KCN medium.
Widely distributed in nature. Isolated from water, soil, foods and clinical samples
(feces, blood, urine, spinal fluid, milk, wound infections) from humans and animals.
(feces, blood, urine, spinal fluid, milk, wound infections) from humans and animals.
Nonpathogenic E. coli is generally located in the intestinal lumen (colon), but some
strains can cause a variety of infections (enteritis, septicaemia, peritonitis, urinary
infections, meningitis etc.) in humans and animals. Large number of O, K, F and H
antigensare recognized. F4 (K88), F5 (K99) - fimbriae - causes enteritis in piglets and
calves. Serotype O157:H7 is pathogenic for humans and animals. E. coli is a toxins
producer and invasive bacteria.
Enterotoxigenic Escherichia coli (ETEC) produces LT and ST toxins.
Verotoxigenic Escherichia coli (VTEC) produce verotoxins (‘Shiga’-like toxins): VT1,
VT2, VTe (SLT1, SLT2, SLT2v); also causes oedema disease in swine.
Enterohemorrhagic Escherichia coli ( (EHEC) causes hemorrhagic colitis and
hemolytic-uremic syndrome.
Enteropathogenic Escherichia coli (EPEC) adhere to intestinal epithelial cells,
causing diarrhoea. Presents the EAE (adherence), EAF (attaching and effacing) and
BFP (bundle-forming pilus) factors. It is an important cause of infant mortality.
Some E. coli 2 (inactive) strains isolated from suckling pigs with diarrhoeic syndrome
were LT (heat-labile toxine) positive.
strains can cause a variety of infections (enteritis, septicaemia, peritonitis, urinary
infections, meningitis etc.) in humans and animals. Large number of O, K, F and H
antigensare recognized. F4 (K88), F5 (K99) - fimbriae - causes enteritis in piglets and
calves. Serotype O157:H7 is pathogenic for humans and animals. E. coli is a toxins
producer and invasive bacteria.
Enterotoxigenic Escherichia coli (ETEC) produces LT and ST toxins.
Verotoxigenic Escherichia coli (VTEC) produce verotoxins (‘Shiga’-like toxins): VT1,
VT2, VTe (SLT1, SLT2, SLT2v); also causes oedema disease in swine.
Enterohemorrhagic Escherichia coli ( (EHEC) causes hemorrhagic colitis and
hemolytic-uremic syndrome.
Enteropathogenic Escherichia coli (EPEC) adhere to intestinal epithelial cells,
causing diarrhoea. Presents the EAE (adherence), EAF (attaching and effacing) and
BFP (bundle-forming pilus) factors. It is an important cause of infant mortality.
Some E. coli 2 (inactive) strains isolated from suckling pigs with diarrhoeic syndrome
were LT (heat-labile toxine) positive.
- J. G. Holt et al., 1994. Facultatively Anaerobic Gram-Negative Rods. Subgroup 1. Family Enterobacteriaceae. In: Begey’s Manual of
Determinative Bacteriology, 9th-edition, Williams & Wilkins, pp 175-189. - Don J. Brenner and J.J. Farmer III, 2001. Family I. Enterobacteriaceae. In: Bergey’s Manual of Systematic Bacteriology, Second
edition, Vol two, part B, George M. Garrity (Editor-in-Chief), pp 587-897. - Leclerc (H.): Étude biochimique d'Enterobacteriaceae pigmentées. Annales de l'Institut Pasteur (Paris), 1962, 102, 726-741.
- Brenner (D.J.) et al.: Atypical biogroups of Escherichia coli found in clinical specimens and description of Escherichia hermannii sp.
nov. J. Clin. Microbiol., 1982, 15, 703-713. - Adeolu M, Alnajar S, Naushad S, S Gupta R. Genome-based phylogeny and taxonomy of the 'Enterobacteriales': proposal for
Enterobacterales ord. nov. divided into the families Enterobacteriaceae, Erwiniaceae fam. nov., Pectobacteriaceae fam. nov.,
Yersiniaceae fam. nov., Hafniaceae fam. nov., Morganellaceae fam. nov., and Budviciaceae fam. nov. Int J Syst Evol Microbiol 2016. - Sorescu I.,Caraivan I., Virgilia Popa, Turcu D., Dorina Tatu-Chiţoiu, Margareta Tonciu, Antoanela Iolanda Tamaş, Pancă C., Stanuica
D., Vlad E., 2000, Characterisation of inactive E. coli isolates from suckling pigs with diarrhoeic syndrome. Studies and
Researches in Veterinary Medicine, 8, 63-68,ISSN-1224-7685.
Glucose and other carbohydrates are fermented with the production of pyruvate, which
is converted into lactic, acetic and formic acids. Part of the formic acid is split into CO2
and H2.
Positive results for catalase, beta-galactosidase, indole production, lysine
decarboxylase, methyl red test, nitrate reduction, acid production from: L-arabinose,
lactose, D-mannitol, D-mannose, D-sorbitol, trehalose and D-xylose.
Negative results for DNase, H2S production, oxidase, urease, Voges-Proskauer
reaction, lipase, gelatinase, citrate utilization, phenylalanine and acid production from:
adonitol, D-arabitol, cellobiose, alpha-methyl-D-glucoside, inositol and erythritol.
Variable results for esculin hydrolysis, ornithine decarboxylase, acid production from
glycerol, melibiose, rhamnose, raffinose and salicin.
is converted into lactic, acetic and formic acids. Part of the formic acid is split into CO2
and H2.
Positive results for catalase, beta-galactosidase, indole production, lysine
decarboxylase, methyl red test, nitrate reduction, acid production from: L-arabinose,
lactose, D-mannitol, D-mannose, D-sorbitol, trehalose and D-xylose.
Negative results for DNase, H2S production, oxidase, urease, Voges-Proskauer
reaction, lipase, gelatinase, citrate utilization, phenylalanine and acid production from:
adonitol, D-arabitol, cellobiose, alpha-methyl-D-glucoside, inositol and erythritol.
Variable results for esculin hydrolysis, ornithine decarboxylase, acid production from
glycerol, melibiose, rhamnose, raffinose and salicin.
(c) Costin Stoica

| Antibiogram |
| Encyclopedia |
| Culture media |
| Biochemical tests |
| Stainings |
| Images |
| Movies |
| Articles |
| Identification |
| Software |
| R E G N U M PROKARYOTAE |
|
E. coli biochemically inactive strains differential characters:
Legend: + positive 90-100%, - negative 90-100%, [+] positive 75-89%, [-] negative 75-89%,
d positive 25-74% of strains, nd not determined.
d positive 25-74% of strains, nd not determined.
|

| Back |
|

|